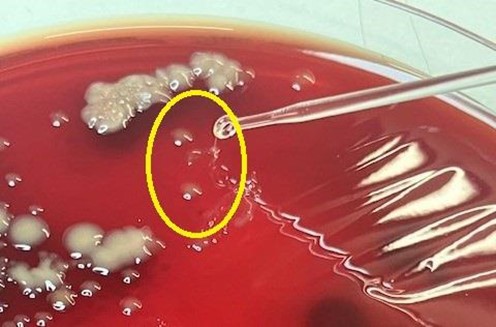

It’s February, which means the year’s coolest water temperatures and usually peak incidence of winter ulcers in farmed salmon populations. But with multiple agents, subtypes and different presentations all linked to winter lesions, the subject can be a clinical challenge.
In this interview, PHARMAQ Analytiq’s Chris Matthews and Khalid Shahin answer questions on the subject of winter lesions, their diagnosis and management.
Winter lesions are occasionally described as ‘typical’ or ‘atypical’- can you explain this?
(CM) ‘Typical’ winter lesions are more common, and generally present as ulcerated lesions of the flanks of fish in seawater, starting small but expanding over several weeks- in some cases becoming very extensive with ulceration deep into the underlying musculature. These generally begin as water temperature cools below 10°C (first cases in Scotland typically appear in November), peaking around February. Healing winter lesions are often characterised by a white, smooth ring of healing epithelium. Typical winter lesions are most often associated with the bacteria Moritella viscosa, but other bacteria are variably involved such as Tenacibaculum and Aliivibrio wodanis.
‘Atypical’ lesions are simply those winter lesions which don’t have the typical flank ulcer appearance. In recent years, I think we’ve seen an increase in Scotland of atypical winter lesion cases where ulceration begins in and around the operculum or jaw, particularly where there are natural folds in the tissue. These cases are mostly associated with Tenacibaculum finnmarkense, which is an opportunistic environmental bacteria which thrives on the calcium-rich bony tissues of the head, although Moritella viscosa is often still detectable by qPCR in these lesions. It’s fairly common to see both typical and atypical lesions in the same case, and we’ve seen cases where atypical lesions appear to follow typical ones- possibly because Tenacibaculum finnmarkense comes to dominate the flank lesions which Moritella starts, then begins attacking the head tissues. We don’t think Tenacibaculum finnmarkense is a true primary pathogen in most cases, although in challenge studies it appears to be able to cause lesions when inoculated onto the skin in high enough amounts (1).

Picture 1: Early winter lesions
Where does Moritella viscosa come from- and how does it cause an ulcer?
(CM) Moritella species are generally found in cold, deepwater marine environments- a fun fact is that Moritella species have been found in sediment samples from the Challenger deep in the Marianas trench. It’s possible that fish farms which naturally experience more deepwater upwelling in winter due to their hydrography are more at risk of winter lesions.
Moritella viscosa forms colonies on the surfaces of scales, secreting enzymes and toxins which break down the structures of the skin. It’s likely that micro-abrasions in the skin, along with loss of robustness occur the more that fish are handled, which means that Moritella is probably better able to colonise and invade fish tissues where fish are handled more frequently. Rough weather in winter, where a subpopulation of fish might contact net surfaces at a time when there is coldwater upwelling, often precedes winter ulcers.
The skin’s natural microbiome plays an important role in defence against Moritella, and we see that when we profile salmon skin bacteria using next generation sequencing (NGS), which we’ve been doing for three years now, then a loss of bacterial diversity often precedes the development of winter lesions by several weeks.
Does Moritella viscosa always cause ulcers?
(CM) There does seem to be a rare presentation of Moritellla viscosa infection in salmon which presents as a peracute disease with high losses and little or no external changes but histological evidence of an acute septicaemia.
We do also occasionally see low levels of M. viscosa in natural microbiome profiles from otherwise healthy fish, so it can be present with the integument and immune system of the fish doing their job- preventing the bacteria from causing pathology.

Picture 2: Internal ecchimotica haemorrhage on the liver, due to Moritella viscosa septicaemia
Why is it the case that qPCR for Moritella viscosa is occasionally negative in cases which look like straightforward winter lesion cases?
(CM) This is because while Moritella initiates the lesion, it can be quickly outcompeted by Tenacibaculum species- so it’s important to collect lesion biopsies or swabs from a number of representative fish when using qPCR to investigate winter lesions.
Interestingly, there are two genomovars of the species Tenacibaculum finnmarkense, called genomovar finnmarkense and ulcerans. PHARMAQ Analytiq’s Inverness lab has developed qPCRs for these two different genomovars, and we can see that the latter, ulcerans, appears to predominate in Scottish and Irish cases of atypical winter lesions. The other, finnmarkense, appears to predominate in Norway (2).
What about other bacteria- are there any others which are significant?
(KS) Another bacteria, Aliivibrio wodanis, has been linked to winter lesions in Norway. It has been proposed that this bacteria somehow augments the ability of Moritella to cause disease- some authors have suggested it slows healing after Moritella viscosa infection (3), but other studies have suggested it may in fact limit the effects of Moritella infection (4). Interestingly, we have not found this bacteria present in Scottish winter lesion cases which have presented to the Inverness lab in recent years.
Picture 3: Classical Moritella viscosa, showing ‘viscous’ or sticky quality to colonies.
Can you explain what is meant by ‘variant’ Moritella viscosa, which has been reported in Norway in recent years?
(KS) Absolutely! Firstly, there may be confusion because we talk about ‘typical’ and ‘atypical’ winter lesion cases, but sometimes also ‘typical’ and ‘variant’ Moritella viscosa, which isn’t the same thing.
There are two primary clades of Moritella viscosa, categorised as ’typical’ or ‘variant’. The ‘typical’ subtype is more usually called ‘classical.’ Historically, the classical subtype was responsible for much of the disease issues in Norway and Scotland, but in recent years the variant subtype began to predominate in Norway- which is significant because the previously available vaccines were based on the classical subtype and offered very little protection against the variant.
In Scotland, both classical and variant subtypes can be responsible for winter lesion cases- occasionally we even identify both in the same case.
How can fish health teams caring for sites experiencing winter lesions identify which Moritella viscosa subtype is responsible?
(KS) We recommend collecting microbiology samples from winter lesion cases, in order to isolate the causative agent. Sending transport swabs is rarely successful however, as the bacteria is outcompeted in the transport media. Plating lesion and carefully collected kidney samples on to seawater blood agar- typically from at least five representative fish per case- is usually enough to grow Moritella viscosa successfully.
When the Moritella colonies grow, we confirm the identity of these colonies with a molecular test as classical or variant. Interestingly, the colonies do look slightly different morphologically when they grow, too, with classical colonies appearing whiter. Clients can also send lesion and kidney biopsies for qPCR identification of Moritella viscosa- however there are three key reasons to take microbiology samples.
Firstly, if it’s classical Moritella growing, we can determine if this is viscous or non-viscous by looking at the colony morphology. Non-viscous classical Moritella viscosa is actually another, newer type of Moritella which has arisen in Norway in recent years, and is relevant to understand because the commercial vaccines currently licensed in the United Kingdom may offer only limited protection to it (and also to variant Moritella viscosa).
Secondly, antibiotic treatment for Moritella is rare but culturing any bacterial pathogen allows us to monitor bacterial resistance by performing an antibiogram if necessary.
Lastly, occasionally both variant and classical Moritella viscosa are occasionally detected together in some cases- microbiology helps demonstrate which is the causative pathogen.

Picture 4: Late-stage winter lesion
Does histopathology play a role in investigating winter lesion cases?
(CM) Both gross pathology and histopathology are important, as it’s crucial to figure out what’s actually killing the fish- occasionally other disease outbreaks can be present in populations with winter sores.
Gross internal pathology in cases of Moritella viscosa are usually consistent with other bacterial septicaemias- so petechial bleeding, swollen spleens etc. However some fish can show more striking ‘chocolate chip’ or ecchymotic bleeding on the liver.
Histologically, Moritella viscosa septicaemias are fairly distinctive so histological sampling should be included to help rule out other causes of mortality.
Generally, it’s best to collect different samples- PCR, microbiology and histopathology- because these each serve a different diagnostic purpose. It’s a bad idea to rely solely on one method for disease diagnostics. For example, early stage skin lesions due to other causes- furunculosis for instance- have historically been confused with winter lesions. PCR from skin biopsies will sometimes test positive for Moritella viscosa even where it is not the cause of the observed pathology- so reliance on PCR alone might cause sites to conclude lesions are winter sores, when in fact they may have other bacterial causes.

Picture 5: Healing winter lesion, showing melanisation of wound margins
How should fish health teams manage outbreaks of winter lesions?
(CM) Preventing is of course always better than curing, so understanding which Moritella viscosa subtypes threaten a site is important when considering vaccination strategy.
Focusing on smolt quality and optimising environmental conditions at transfer to sea, alongside minimising handling during the coldest months may help prevent lesions. If lesions do appear, prompt removal from the cage of affected individuals where possible probably slows potential transmission.
When in clinical practice, where we’ve seen winter lesions develop fish were given diets with boosted vitamins E and C, and there is some evidence that this promotes tissue regeneration and wound repair. Beta-glucan supplementation also shows promise for mitigating the impact of winter ulcers, although this needs more research. Vets may also consider antibiotics for populations under their care with winter lesions- the very few papers published on this suggest little effect in reducing mortality (5), though my own experience is that in some cases where primary Moritella septicaemia is driving mortality (rather than opportunistic secondary bacteria from chronic lesions) there has been benefit.
References
(1) Smage, S.B., Frisch, K., Vold, V., Duesund, H., Brevik, O.J.,Olsen, R.H., Sjaatil, S.T., Klevan, A., Brudeseth, B., Watanabe, K., Nylund, A. (2018) Induction of tenacibaculosis in Atlantic salmon smolts using Tenacibaculum finnmarkense and the evaluation of a whole cell inactivated vaccine. Aquaculture, Volume 495, 1 October 2018, 858-864
(2) Spilsberg, B., Nilsen, H. K., Tavornpanich, S., Gulla, S., Jansen, M. D., Lagesen, K., Colquhoun, D. J., & Olsen, A.-B. (2022). Tenacibaculosis in Norwegian Atlantic salmon (Salmo salar) cage-farmed in cold sea water is primarily associated with Tenacibaculum finnmarkense genomovar finnmarkense. Journal of Fish Diseases, 45, 523–534.
(3)Toranzo, A.E.; Magariños, B.; Romalde, J.L. A review of the main bacterial fish diseases in mariculture systems. Aquaculture 2005
(4)Hjerde, E.; Karlsen, C.; Sørum, H.; Parkhill, J.; Willassen, N.P.; Thomson, N.R. Co-cultivation and transcriptome sequencing of two co-existing fish pathogens Moritella viscosa and Aliivibrio wodanis. BMC Genom. 2015, 16, 447.
(5)Coyne, R.; Smith, P.; Dalsgaard, I.; Nilsen, H.; Kongshaug, H.; Bergh, Ø.; Samuelsen, O. Winter ulcer disease of post-smolt Atlantic salmon: An unsuitable case for treatment? Aquaculture 2006, 253, 171–178.
PHARMAQ is the global leader in vaccines and innovation for aquaculture and part of Zoetis, the world leader in animal health. The company provides environmentally sound, safe and efficacious health products to the global aquaculture industry through targeted research and the commitment of dedicated people. Production facilities, administration and research and development activities are based in Norway with subsidiaries in Chile, United Kingdom, Vietnam, Turkey, Spain, Panama and Hong Kong. PHARMAQ has approximately 300 employees. The company's products are marketed in Europe, North and South America, and Asia. For further information, visit the company's website at www.pharmaq.com. Privacy Policy. Cookie Policy. Terms of Use.
Copyright © 2020 Zoetis LLC. All rights reserved.